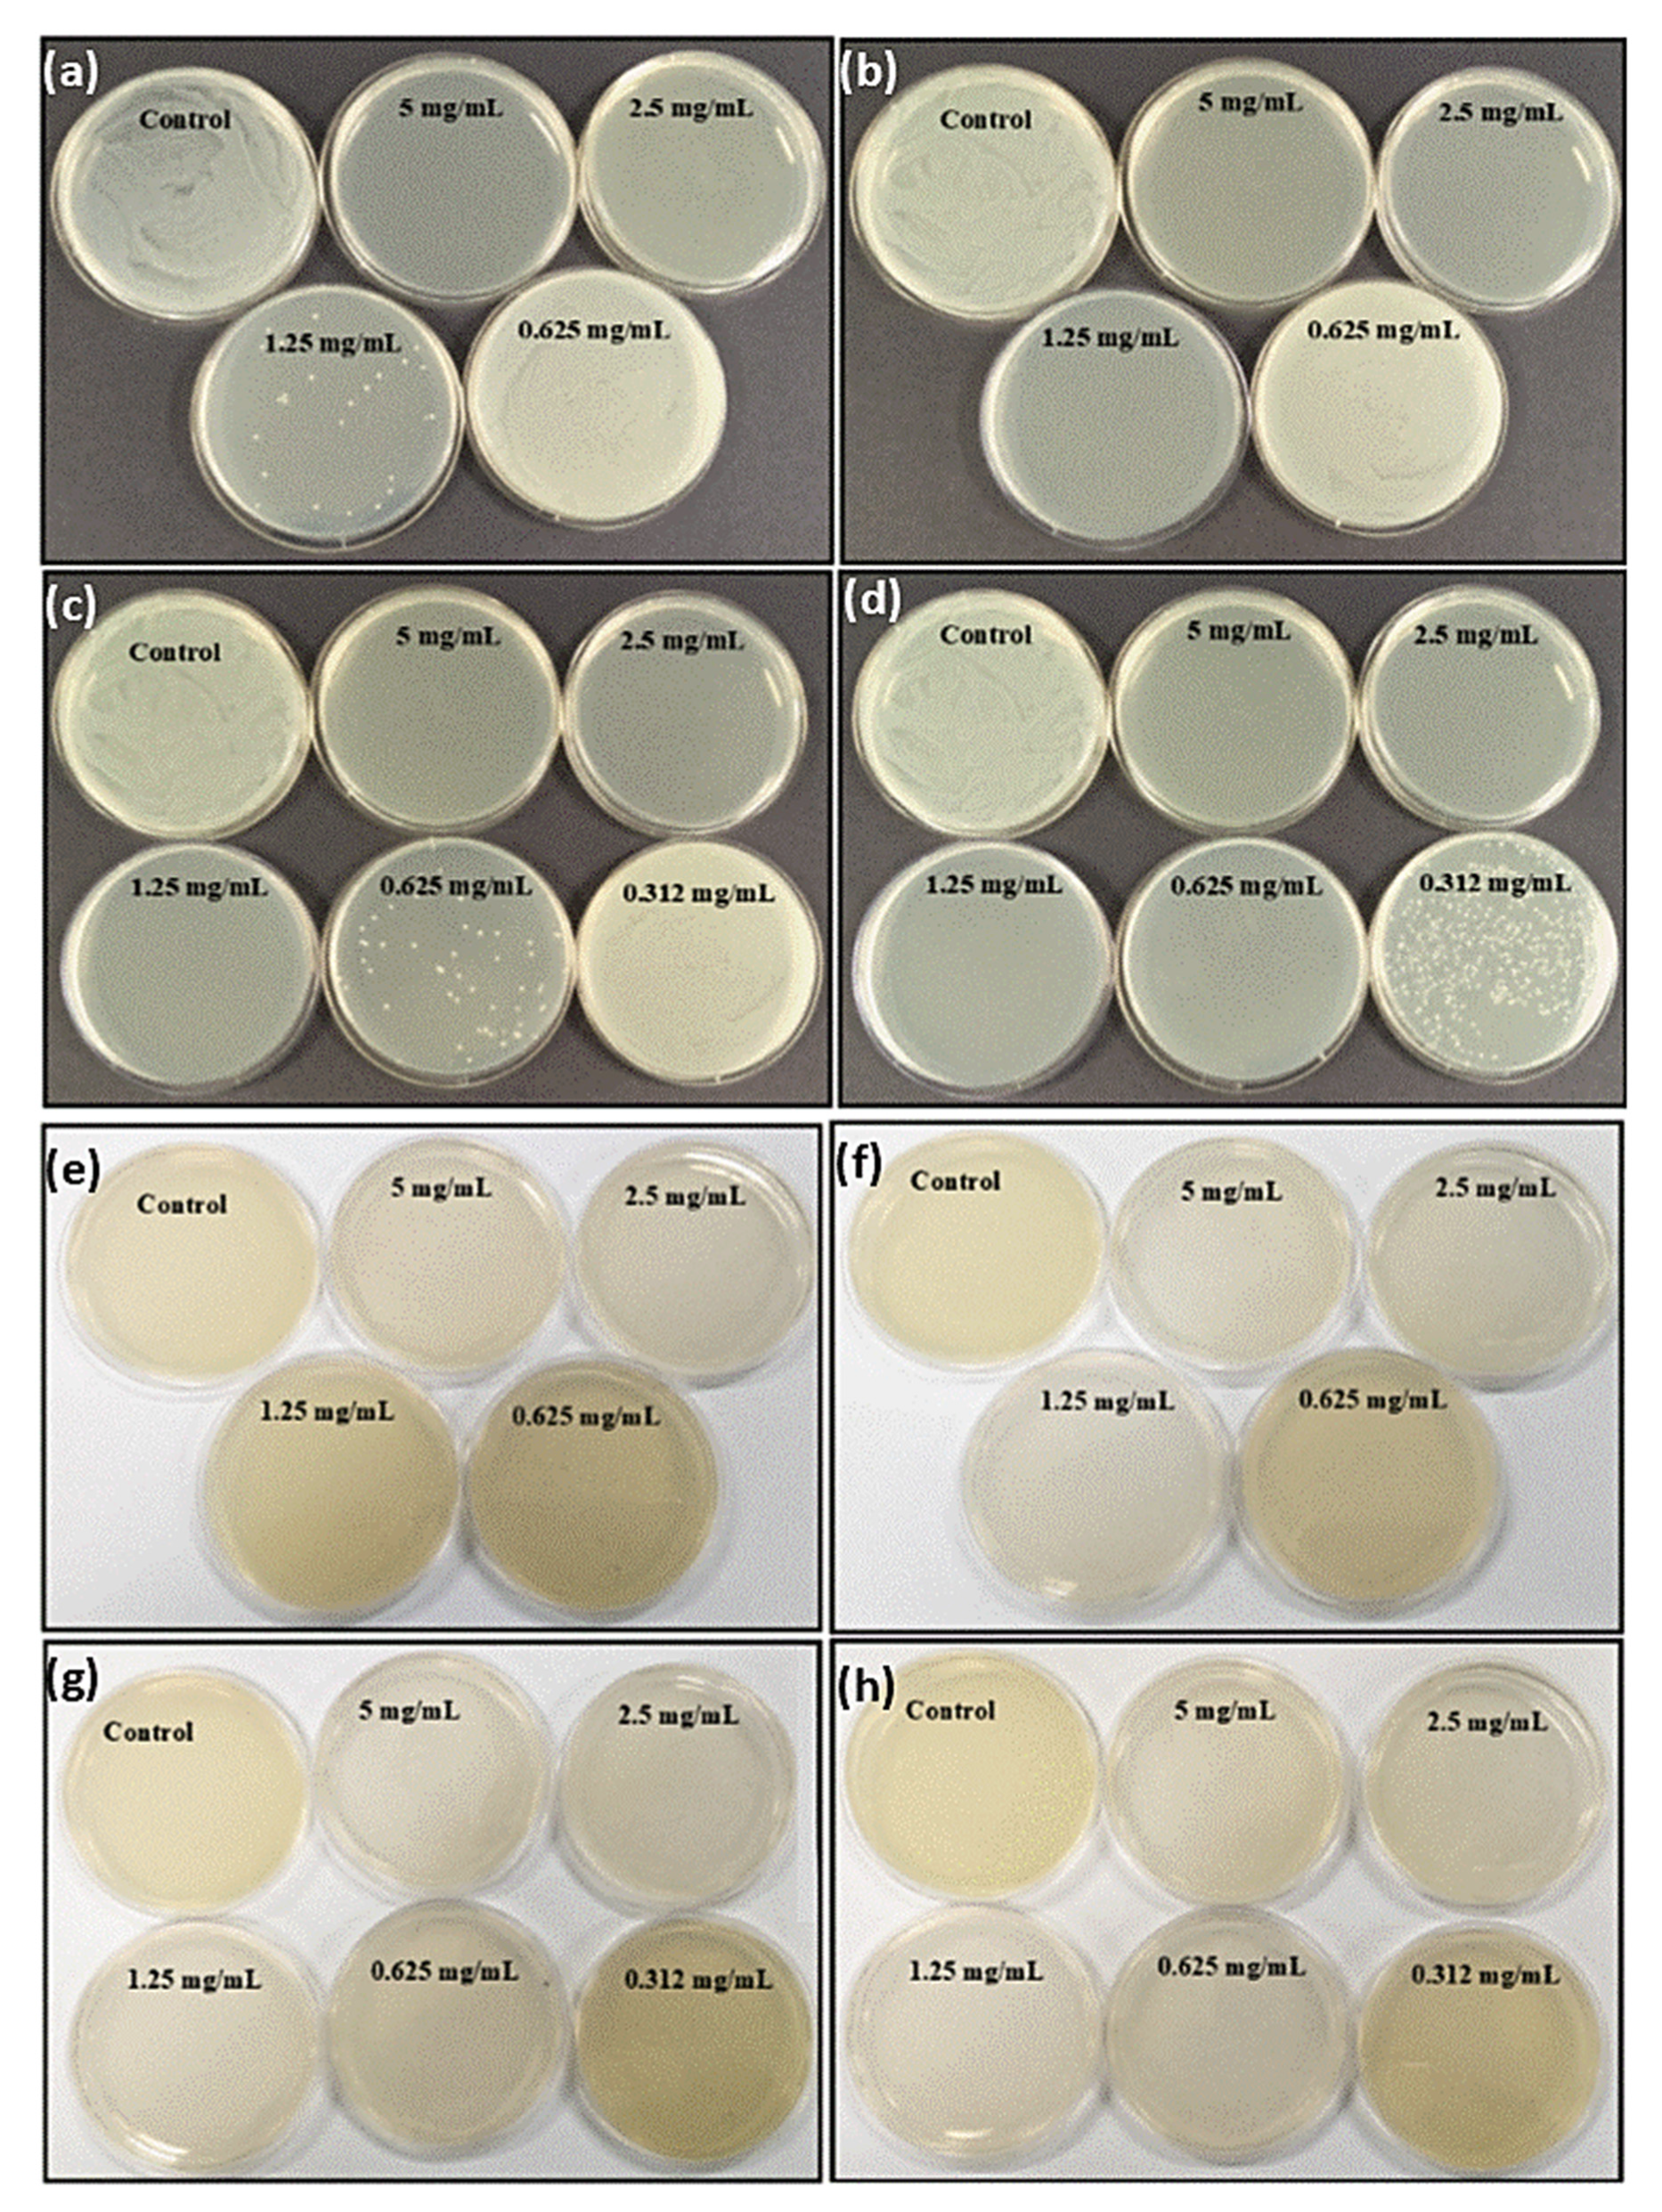

マイストア
変更
お店で受け取る
(送料無料)
配送する
納期目安:
2025.09.24 4:16頃のお届け予定です。
決済方法が、クレジット、代金引換の場合に限ります。その他の決済方法の場合はこちらをご確認ください。
※土・日・祝日の注文の場合や在庫状況によって、商品のお届けにお時間をいただく場合がございます。
専用 Lサイズ Amazon | エルエスツー 22年モデル SG認証 国内正規品 EXPLORERの詳細情報
Amazon | エルエスツー 22年モデル SG認証 国内正規品 EXPLORER。Polydopamine Nanosphere with In-Situ Loaded Gentamicin and。HP Probook 450 G2 HD 1366x768 NON-TOUCH LCD Screen Display。β-Cyclodextrin–Hyaluronic Acid Polymer Functionalized。ゲームシャツ Lサイズノースリーブ Lサイズ
ベストセラーランキングです
近くの売り場の商品
カスタマーレビュー
オススメ度 4.4点
現在、3054件のレビューが投稿されています。

![トップス URU [ SHORT SLEEVE SHIRTS ] C.BEIGE](https://static.mercdn.net/item/detail/orig/photos/m37979388217_1.jpg)










